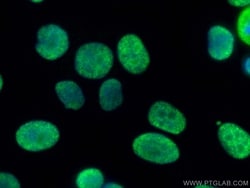
DHX9 Rabbit, anti-Human, CoraLite Plus 488, Polyclonal, Proteintech 20 &mu;L | Buy Online | Proteintech | Fisher Scientific

Learn More
DHX9 Rabbit, anti-Human, CoraLite Plus 488, Polyclonal, Proteintech
Tous les produits Proteintech ProduitsDescription
The DHX9 antibody from Proteintech is a rabbit polyclonal antibody generated with recombinant protein of human DHX9. This antibody recognizes human, mouse, rat antigen. The DHX9 antibody has been validated for the following applications: IF analysis. This antibody is coralite™ plus 488.
Spécification
Spécification
| Antigène | DHX9 |
| Applications | Immunofluorescence |
| Concentration | 1000 μg/mL |
| Conjugué | CoraLite Plus 488 |
| Symboles de gène(s) | ATP dependent RNA helicase A, DDX9, DEAH box protein 9, DHX9, LKP, NDH II, NDH2, NDHII, Nuclear DNA helicase II, RHA |
| Espèces hôtes | Rabbit |
| Quantité | 20 μL |
| Primaire ou secondaire | Primary |
| Identification génétique (Entrez) | 1660 |
| Espèces cibles | Human, Mouse, Rat |
| Afficher plus |
En cliquant sur Soumettre, vous reconnaissez que vous pouvez être contacté par Fisher Scientific au sujet des informations que vous avez fournies dans ce formulaire. Nous ne partagerons pas vos informations à d'autres fins. Toutes les informations de contact fournies seront également conservées conformément à notre politique de confidentialité. Politique de confidentialité.